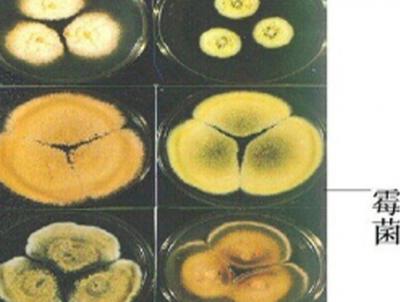
次氯酸消毒液

行業新聞
凈菜也稱新鮮消毒蔬菜,即將新采摘的蔬菜經過整理(如去掉不可食部分、切分等)、洗滌、消毒等加工操作,在無菌環境中,真空包裝而制成的一種產品。凈菜必須滿足“八無八有”的原則,八無是指農藥殘留超標、無重金屬殘留超標、無亞硝酸鹽殘留超標、無其他污染、無青幫老葉、無泥沙、無雜物、莖葉類菜無根須,八有則是指有生產標準、有產銷記錄、有質量檢測、有產品包裝、有采收和保質日期、有注冊商標、有食用說明、有冷鏈儲運。當前行業現狀近年來,凈菜加工已被認為是今后蔬菜業發展的重要方向之一。在產業扶貧方面,發展凈菜產業,可增加農民收入,加速三產融合。在城市環境治理方面,發展凈菜產業,將減少垃圾進城。總體來說,蔬菜中30%
2023/08/17 08:43
霉菌作為生活中常見的一類微生物,是形成分枝菌絲類真菌的統稱,它們往往能形成分枝繁茂的菌絲體,但又不象蘑菇那樣產生大型的子實體。霉菌喜溫喜濕,在溫暖和潮濕環境下都能夠生長和繁殖,因此食物、飼料、家具、衣物,甚至墻面、地板在潮濕的季節都極容易發生霉變。其中,部分霉菌在生長繁殖過程中會產生一類有毒性的次級代謝產物,稱之為霉菌毒素。這些霉菌毒素通過食品、飼料等進入人和動物體內,引起人和動物的急性或慢性毒性,損害機體的肝臟、腎臟、神經組織、造血組織及皮膚組織等,從而威脅生物體生命。目前發現約有150余種可以產生毒素的霉菌,所產生的霉菌毒素種類超過300種,其中就最著名的就是“頭號殺手“黃曲霉毒素。
2023/08/16 08:35
近年來,隨著養殖水平的不斷提高,我國養殖業已進入一個快速發展的時期,但由于養殖場規模集約化、高密度飼養,使養殖場的病原體不斷復雜,而這些病原微生物在適當條件下能造成疫病的流行,如豬瘟、口蹄疫、豬藍耳病、豬圓環病毒、禽流感、高熱病等,病原微生物傳播的速度也越快,傳染病一旦爆發,再采取措施往往也就來不及了,將造成嚴重的經濟損失。消毒,是疾病綜合預防中的一個重要環節,通過科學的、合理的、有效的消毒,切斷傳染病的傳播途徑,減少養殖場和雛禽舍病原微生物的數量,就可以在一定程度上減少或者避免傳染病的發生。我國目前多采用化學消毒劑對畜禽養殖場環境進行消毒。化學消毒劑和藥物的濫用,常導致耐藥病原微生物的產生
2023/08/15 08:40
空氣中存在三類污染:生物性污染,化學污染及物理性污染。其中生物性污染是影響最快、影響面最廣、危害性最大的污染。微生物在室內孳生、繁殖后污染空氣,可引起人們出現眼刺激感、過敏、哮喘、皮炎以及病態建筑綜合癥,甚至可導致死亡。目前,室內微生物污染已成為重要的環境衛生問題,成為人們關注的熱點之一。人類許多傳染病都是經空氣傳播的,世界上41種主要傳染病中,有14種以空氣傳播為首位,2003年帶給人類巨大損失的SARS以及當下全球流行的2019-nCoV就是經空氣以飛沫為主要的傳播途徑。室內空氣微生物主要來源于以下3個方面:一是飛沫,人在深呼吸、說話、打噴嚏時,會將寄生于人口腔、
2023/08/14 11:17
盛懷次氯酸發生器,采用無隔膜式恒溫電解技術(稀鹽酸款),可持續產生具有高效殺菌特性的機能水。盛懷次氯酸消毒科技優先確保安全的前提下,以消殺凈為目的而研發生產的消毒液,其主要殺菌因子是次氯酸,與人體自身部分免疫功能成分相同,顯強氧化性且不帶電荷,是中性小分子,不受致病菌細胞壁負電荷干擾,可快速穿透細胞膜進入細胞內部,迅速釋放活性氧,使致病菌死亡,因此,微酸性次氯酸水與人體有高度的相容性,安全性高,無刺激、無殘留、無副作用。它在2012年被美國FDA列入可有效接觸食品認定目錄。目前,中國已經成為全球水產品的主要生產國,2016年中國水產品產量達到6901萬噸,占全球比重超過40%。
2023/08/11 08:44